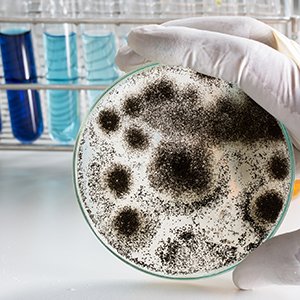

Mold toxins can suppress the immune system
Microfungi, i.e. mold, produces mycotoxins, which can wreak havoc on essentially any system in the body, leading to a confusing malaise of chronic symptoms, from headaches and allergies to autoimmune conditions.
Microfungi, i.e. mold, produces mycotoxins, which can wreak havoc on essentially any system in the body, leading to a confusing malaise of chronic symptoms, from headaches and allergies to autoimmune conditions.
Mold toxins can suppress the immune system, damage and kill cells, cause cancer and birth defects, and impair mitochondrial function and the nervous system.
Mold-related illnesses are often difficult to pinpoint, since few conventional physicians are trained to recognize or treat them.
At Forum Health our integrative physicians are experts at diagnosing and treating mold toxicity. Through research-backed tests, cutting-edge detox methods, and other therapies that strengthen the immune system, we’ll guide you back to good health.


